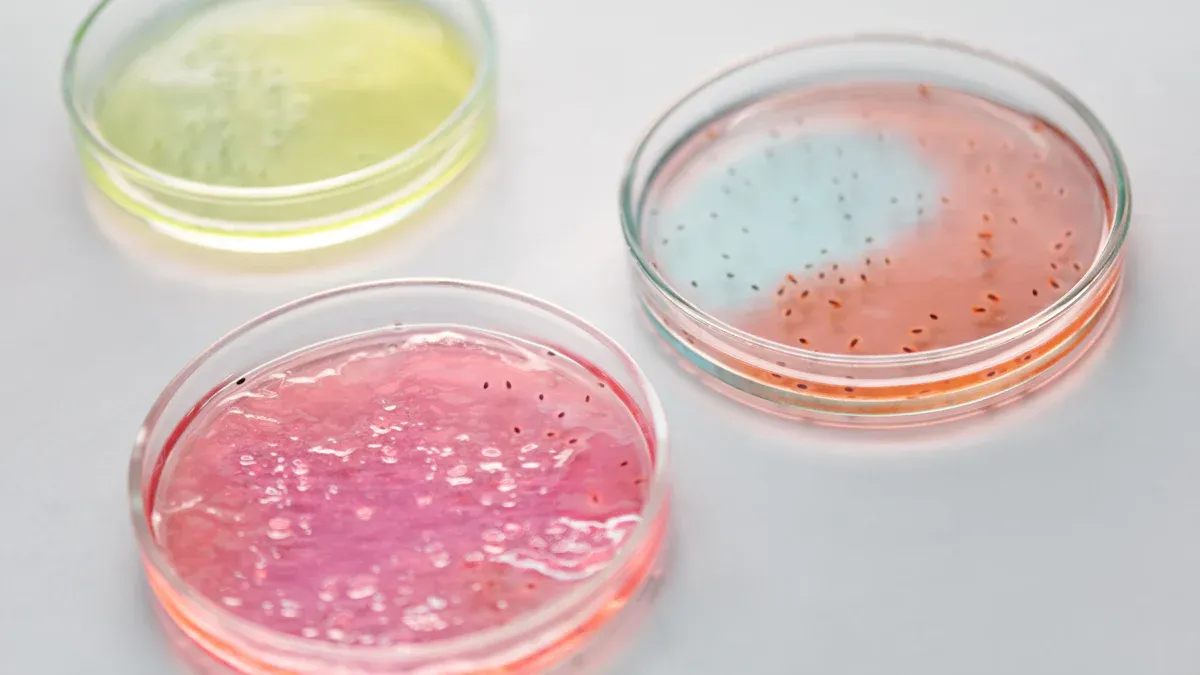
Preparing

Quick Guide to Using Vegetarian Gelatin Powder Instead of Gelatin

You might want to swap animal-based gelatin for vegetarian gelatin powder. The main difference comes from ingredients—one uses plants, the other uses animal collagen. Check out this quick table for converting agar powder to traditional gelatin:
| Agar Powder | Traditional Gelatin |
|---|---|
| 1 teaspoon (≈ 2 g) | 1 standard 0.25-oz (7 g) envelope |
Key Takeaways
- Use agar agar as a popular vegetarian substitute for traditional gelatin. It sets at room temperature and creates a firm texture.
- Follow a 3:1 substitution ratio: for every 1 part animal gelatin, use 1/3 part agar powder to achieve the desired consistency.
- Always bloom agar powder in cold liquid before heating to prevent lumps and ensure a smooth texture in your desserts.
What Is Vegetarian Gelatin Powder?

Common Types of Vegetarian Gelatin Powder
You might wonder what goes into vegetarian gelatin powder. You can find a few main types in stores. Here are some common ingredients:
- Agar agar: This comes from red algae. People use it as a vegetarian and vegan substitute for gelatin.
- Hypromellose: You may see this in capsules. It works as a vegetarian-friendly alternative.
Agar agar is the most popular choice for home cooks. You can use it in desserts, jellies, and even savory dishes. Hypromellose shows up more in supplements and capsules.
Carrageenan is a versatile hydrocolloid with applications across multiple industries: It is widely used as a stabilizer, thickener, and gelling agent in dairy and non-dairy products such as ice cream, yogurt, plant-based milk, and sauces.
Differences Between Vegetarian and Animal Gelatin
You will notice some big differences when you swap animal gelatin for vegetarian gelatin powder. Agar sets at room temperature and forms a firm gel. Gelatin needs refrigeration and makes a soft, elastic gel. Agar also needs boiling water to dissolve, while gelatin melts at lower temperatures.
The gelling properties of agar also differ from gelatin. Agar creates a brittle gel, while gelatin forms a bouncier, more elastic texture. This results in distinct mouth feels, with agar being firmer and gelatin being softer.
Here’s a quick look at how they set:
| Type of Gelatin | Setting Method | Setting Temperature |
|---|---|---|
| Vegetarian Gelatin | Sets at room temperature after boiling | Room temperature |
| Animal Gelatin | Requires cooling to set, melts at lower temperature | Below 30–35 °C (86–95 °F) |
You can see that vegetarian gelatin powder gives you a firmer texture and sets faster at room temperature.
Vegetarian Gelatin Powder Conversion Ratios
Switching from animal gelatin to vegetarian gelatin powder can feel tricky at first. You might wonder how much to use or if your dessert will set the same way. Don’t worry! With a few simple guidelines, you can get great results every time.
Agar Powder Substitution Guide
Agar powder is the most popular vegetarian gelatin powder for home cooks. You can use it in everything from fruit jellies to panna cotta. The key is knowing the right ratio. If your recipe calls for animal gelatin, you usually need less agar powder.
Here’s a quick guide to help you swap gelatin for agar:
- Use a 3:1 ratio. For every 1 part animal gelatin, use 1/3 as much agar powder.
- To thicken 1 cup of liquid, use 1 teaspoon of agar powder.
- If you have agar flakes, use 1 tablespoon per cup of liquid.
Tip: Agar sets much firmer than gelatin. If you want a softer texture, use a little less agar powder.
You’ll notice that agar-based desserts feel different. Gelatin gives you a soft, jiggly bite. Agar makes a firmer, more brittle gel that slices cleanly. Here’s a quick comparison:
| Feature | Gelatin | Agar Agar |
|---|---|---|
| Texture | Elastic, jiggly, melt-in-mouth | Firm, brittle, clean slice |
Carrageenan Substitution Guide
Carrageenan is another plant-based gelling agent. You’ll see it in many store-bought puddings and dairy-free desserts. If you want to use carrageenan at home, you need to know the right amount.
For every cup of liquid, use:
| Ingredient | Amount for 1 cup of liquid |
|---|---|
| Carrageenan | 1 ounce |
| Regular Gelatin | 1-3 teaspoons |
Carrageenan sets at a higher temperature than animal gelatin. It creates a strong gel, but the texture feels different. Gelatin melts in your mouth, while carrageenan holds its shape even at room temperature.
Note: Animal gelatin starts to set around 37°C (about body temperature). Carrageenan stays firm even when things get warm.
Quick Reference Table for Vegetarian Gelatin Powder
You don’t have to guess how much vegetarian gelatin powder to use. Check out this handy table for common desserts. It shows how much gelatin, agar powder, and other forms you need for different textures.
| Recipe Type | Gelatin (Powder) | Agar-Agar Powder | Agar Flakes | Agar Bars |
|---|---|---|---|---|
| Soft-Set Jelly | 1 Tbsp | ½ tsp | 1 tsp | ¼ bar |
| Firm Jelly | 1 Tbsp | 1 tsp | 1 Tbsp | ½ bar |
| Panna Cotta | 1 Tbsp | ¾ tsp | 1½ tsp | ⅓ bar |
| Savory Terrine | 1 Tbsp | 1 tsp | 1 Tbsp | ½ bar |
| Fruit Gummies | 1 Tbsp | 1 tsp | 1 Tbsp | ½ bar |
You can also use this quick chart for single-cup conversions:
| Texture target | Gelatin amount* | Agar powder equivalent |
|---|---|---|
| Soft set (panna-cotta) | ½ tsp | ¼ tsp (≈ 0.5 g) |
| Firm dessert jelly | 1 tsp | 1 tsp (≈ 2 g) |
| Sliceable terrine / aspic | 2 tsp | 1½ tsp (≈ 3 g) |
*Based on one cup (240 ml) of liquid.
Pro tip: Always dissolve agar powder in boiling liquid for best results. If you use too much, your dessert may turn out too firm.
With these ratios, you can confidently use vegetarian gelatin powder in your favorite recipes. Try different amounts to find the texture you like best!
Preparing Vegetarian Gelatin Powder
Dissolving Vegetarian Gelatin Powder
You want your desserts to turn out smooth and lump-free. Start by blooming the powder. Sprinkle it evenly over cold or room-temperature liquid. This step helps prevent clumps. After blooming, heat the mixture gently. Keep the temperature between 95°F and 105°F (35°C to 40°C). If you heat it too much, the gelling power drops. Never let it boil. If you see lumps, pour the mixture through a fine-mesh sieve.
Here’s a quick table to help you remember:
| Best Practice | What to Do |
|---|---|
| Blooming | Sprinkle over cold/room-temp liquid |
| Temperature Control | Heat gently, keep below 140°F (60°C) |
| Avoiding Lumps | Strain if needed, stir until dissolved |
| No Boiling | Boiling ruins the gelling ability |
Mixing and Incorporating into Recipes
After you dissolve the powder, you need to mix it into your recipe. Follow these steps for best results:
- Hydrate the powder in cold water first.
- Stir until the powder dissolves completely.
- Add the dissolved mixture to your recipe and mix well.
This way, you get even texture and no grainy bits.
Setting and Cooling Tips
Let your dessert cool and set for the right amount of time. Most recipes need about 6 hours in the fridge. For best results, follow these steps:
| Step | What to Do |
|---|---|
| 1 | Place 1/4 cup cold water in a bowl |
| 2 | Sprinkle powder and let bloom for 5–10 minutes |
| 3 | Heat gently, then mix with other liquids |
| 4 | Chill for 6 hours to set |
With these tips, you can use vegetarian gelatin powder like a pro.
Recipe Adjustments with Vegetarian Gelatin Powder
Adjusting Texture and Firmness
You want your dessert to have the perfect bite. When you use vegetarian gelatin powder, you need to pay attention to the type you choose. Each one acts a little differently. Here are some things to keep in mind:
- Agar agar sets desserts very firm and slices cleanly.
- Carrageenan comes in different types. Iota works well with fruits and dairy. Kappa gives a strong set in milk-based recipes. Lambda thickens but does not set firm.
- You need to use different amounts than you would with animal gelatin. Always check the package or a recipe for the right measurement.
If you want a softer texture, use a little less powder. For a firmer set, add a bit more. Try small test batches to see what you like best.
Flavor Considerations
You might notice a slight taste difference when you use vegetarian gelatin powder. Agar agar has almost no flavor, so it works well in sweet or savory dishes. Carrageenan can sometimes add a hint of sea flavor, but it usually blends in with other ingredients. If you want to hide any taste, add a splash of vanilla or citrus juice.
Tip: Taste your mixture before you let it set. You can adjust the flavor with a little extra sugar or extract if needed.
Setting Time Differences
Vegetarian gelatin powder sets much faster than animal gelatin. Agar agar starts to gel as it cools to room temperature. You do not need to wait hours for it to firm up. Carrageenan also sets quickly, especially in dairy recipes. Keep an eye on your dessert as it cools. You might need to pour it into molds right away before it gets too thick.
Troubleshooting Vegetarian Gelatin Powder Issues
Fixing Improper Setting
Sometimes your dessert just won’t set right. Don’t worry—you can fix it! Here are some common reasons and quick solutions:
- Fresh pineapple, kiwi, or papaya can stop your gelatin from setting. These fruits have enzymes that break down the gelling agent.
- Use canned fruit instead. The canning process destroys those tricky enzymes, so your dessert will set perfectly.
- Frozen fruit might still have active enzymes. It’s best to stick with canned if you want a firm gel.
- If your mixture still won’t set, try reheating it gently and adding a bit more vegetarian gelatin powder. Pour it back into your mold and let it chill again.
Tip: Always check your fruit before adding it to your recipe!
Dealing with Cloudy Appearance
You want your jelly to look clear and pretty. Cloudiness can happen if you don’t dissolve the powder the right way. Try these steps:
- Sprinkle the powder over cold water. Let it sit and bloom—don’t stir right away.
- Avoid dumping the powder in one spot. Spread it out so you don’t get lumps.
- After blooming, slowly add hot water while stirring. Keep stirring until the mixture looks clear.
A little patience here gives you a beautiful, see-through dessert.
Managing Flavor Changes
Sometimes vegetarian gelatin powder can change the taste of your dish. Agar agar usually has no flavor, but other powders might add a slight seaweed note. If you notice a taste you don’t like, add a splash of lemon juice or a bit more sugar. Vanilla extract also helps cover up any odd flavors. Taste your mixture before it sets so you can adjust it easily.
Remember: Small tweaks can make a big difference in your final dessert!
You can master vegetarian gelatin powder with a few simple tricks:
- Use agar powder for best results.
- Swap one teaspoon of agar for every three teaspoons of gelatin.
- Boil your liquid and whisk well.
Check out how it compares in the kitchen:
| Property | Animal Gelatin | Vegetarian Gelatin (Agar-Agar) |
|---|---|---|
| Texture | Soft, elastic | Firm, sliceable |
| Heat Resistance | Low | High |
| Dietary Suitability | Not vegan-friendly | Vegan and vegetarian |
Try new recipes and see how easy it is to create tasty treats!
FAQ
Can you freeze desserts made with vegetarian gelatin powder?
You can freeze them, but the texture might change. Agar-based desserts may become watery after thawing. Try chilling in the fridge for best results.
Does vegetarian gelatin powder work in savory recipes?
Yes! You can use it in savory dishes like aspic, terrines, or even vegan cheese. Just follow the same dissolving and setting steps.
Is vegetarian gelatin powder gluten-free?
Most vegetarian gelatin powders, like agar agar, are naturally gluten-free. Always check the label to make sure there are no added ingredients.
See Also
10 Creative Methods for Incorporating Bovine Gelatin Powder
Comparing Bovine Gelatin Powder with Fish and Pork Options
Understanding the Composition and Production of Bovine Gelatin